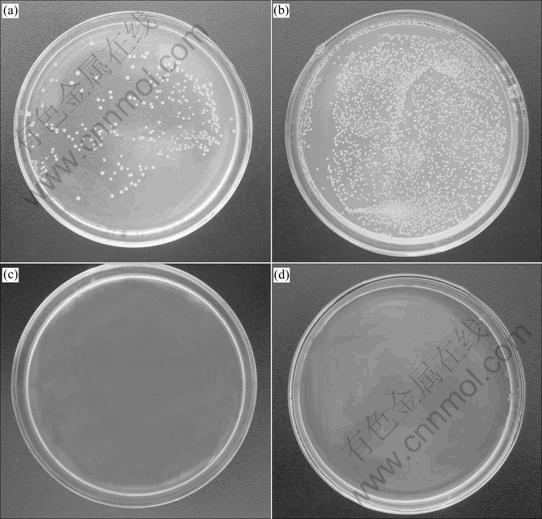

Effect of thermal treating temperature on characteristics of silver-doped titania
CHAI Li-yuan(����Ԫ)1, WEI Shun-wen(Τ˳��)1, PENG Bing(�� ��)1, LI Zhu-ying(����Ӣ)2
1. School of Metallurgical Science and Engineering, Central South University, Changsha 410083, China;
2. Yiwu Bureau of Quality and Technical Supervision, Yiwu 322000, China
Received 6 November 2006; accepted 22 January 2008
Abstract:
The silver-doped titania antibacterial agent was synthesized by mixing silver nitrate and the precursor of titania. Effects of thermal treatment on the properties of the silver-doped titania powders were investigated by thermal gravimeter/differential thermal analyzer(TG/DTA), scanning electron microscope(SEM), and X-ray diffractometer(XRD), respectively. The results show that the anatase phase forms in titania when the powder is calcined at 400 ��. With the increase of the calcination temperature from 400 to 700 �� , the grains of titania agglomerate and the particle size increases from 14 to 23 nm, and the specific surface area decreases from 63 to 38m2g. As the powder is calcined at 700 ��, titania starts to transform from anatase to rutile phase. The release rate of silver ion of powder treated at the relatively low temperature is larger than that of powder treated at the relatively high temperature. The antibacterial tests show that the antibacterial activity of silver-doped titania powders is excellent against E.coli and S. aureus, and the antibacterial activity of powders weakens with the increase of the calcination temperature.
Key words:
silver ion; titanium dioxide; antibacterial material;
1 Introduction
Titanium dioxide is one of the most important inorganic materials with high refractive index, chemical stability and photocatalytic activity. It has been widely applied in solar cell[1-2], luminescent material[3] and photocatalyst for photolysis of water [4] or organic compounds for bacteriocidal action[5]. However, its wide band-gap energy means that only 5% of solar spectrum is used. For practical application, the photocatalytic activity of titanium dioxide needs further improvement. So recently, there are many attempts[6-7] to improve the photocatalytic activity of titanium dioxide by doping, surface modification, depositing metals such as Ag, Pd, Pt, Ni, rare-earth elements.
It is well-known that silver has a broad spectrum antibacterial activity and exhibits low toxicity towards human cells, and a variety of silver compounds has been used as a disinfectant for treatment of infectious diseases. While titanium dioxide is doped by silver, the silver-doped titanium dioxide powder can show a marked antibacterial activity even without the presence of light. However, there are few literatures[8-10] focusing on antibacterial activity of silver-doped titania materials; moreover, the silver-doped titania material was produced in different ways (sol-gel, ion-exchange, melting) and its antibacterial activity was various because it was affected by the conditions of their synthesis and preparation methods of titanium dioxide, including the effect of reactants (sulfate, chloride and organic derivatives). Hence, a study on the characteristics of silver-doped titania materials prepared by mixing silver ion with the precursor of titania was conducted in this work. Special attention was paid to the effect of thermal treatment on the structure, morphology, release rate of silver ion and antibacterial activity of composite.
2 Experimental
2.1 Composite synthesis
The colloid H2TiO3 was prepared by forced- hydrolysis of titanium sulfate solution(TiO2 30 g/L, H+ 3 mol/L) in autoclave at 125 �� for 2 h. The mean size of H2TiO3 particles measured by particle size analyzer (MS-2000) is 0.2 ��m, and the specific surface area is 113.8 m2/g. Preparation of 10 g/L silver solution was made by dissolving 1.574 g AgNO3 into 0.01 mol/L HNO3 and making the volume to 1 L. The appropriate volume of 10 g/L AgNO3 solution was added to the colloid H2TiO3 and mixed to obtain the mixture containing 3% Ag (mass fraction). This mixture was ultrasonically stirred for 30 min. After drying at 100 �� for 24 h, the mixture was placed in an electric tubular furnace and heated to 400, 500, 600 and 700 ��, respectively. The temperature was increased at the rate of approximately 8 ��/min. Upon reaching the desired temperature the samples were left in the furnace for 2 h and then taken out for analysis.
2.2 Particle characterization
The thermal behavior of the prepared particles was detected using differential scanning calorimetry analysis (SDT-Q600). Small portions (8-10 mg) of test samples were placed in shallow aluminium pans and were analyzed by heating at a 10 ��/min rate to 600 �� in air. The heat flow in the sample cell was measured as a function of time.
The major phase of the prepared particles was determined by using X-ray diffraction patterns (Philips PW1780 diffractometer). The mean crystallite sizes of titania were estimated by analyzing the broadening of the (101) reflection. The average particle size can be calculated by the Scherrer law:
![]() (1)
(1)
where �� is the wavelength of X-ray source (Cu K��, 1.054 056 ?), and �� is the full-width at half-maximum of the X-ray diffraction peak at the diffraction angle ��.
The specific surface area(SSA) of the particles was determined by a low temperature gas(nitrogen) adsorption technique and calculated using the BET equation. The morphology of the particles was characterized by the scanning electron microscopy(SEM).
2.3 Release of silver ions from particles
The silver release profile of the particles annealed at various temperatures was examined. 1 g powder was soaked in 200 mL of distilled water in a polypropylene bottle at 37 �� and stirred mechanically at 120 r/min. At each time period(1 d), the distilled water was filtered through filter paper and analyzed on silver ion concentration by atomic absorption spectrophotmeter (AAS).
2.4 Antibacterial activity test
For microbiological experimentation, E.coli (ATCC 25922) and S.aureus (ATCC 6538) were selected as indicators. Gram-negative E. coli was chosen because gram-negative bacteria are responsible for more than 80% of infections. Antibacterial test was performed by attachment method. All glass wares and materials were sterilized in autoclave at 121 �� for 30 min before experiments. 0.1 g of the silver-contained materials were put into 10 mL distilled water containing about 105 cfu (colony forming units)/mL of E. coli and then shaken at 37 �� for 2 h. 0.1 mL treated solution was taken out and diluted with distilled water to a certain volume (to adjust the bacterial concentration of the treated solution and ensure the bacterial colonies grown could be counted easily and correctly). The diluted solution was then spread in a 15 mL Mueller-Hinton(MH) agar plate and cultivated with microorganisms at 37 �� for 24 h. Subsequently, the plate was taken out and the number of bacterial colonies was counted. Each evaluation was carried out in triplicate and the values obtained were averaged to give the final data.
3 Results and discussion
3.1 Thermal analysis
Fig.1 shows the DTA and TG traces for silver- doped titania powders. It can be seen from Fig.1 that there are four endothermic peaks in the DTA trace. The first two peaks in the temperature range of 100-300 �� can be attributed to the surface hydroxyl group and adsorbed water lost in silver-doped powder and combine with the simultaneous 9.526% mass loss in the TG traces. Meantime, the amorphous titania transforms into anatase phase. The largest exothermal peak of the DTA trace in the temperature region of 300-500 �� can be attributed to the decomposition of silver nitrate and the structural hydroxyl group of titania precursor, and combine with the simultaneous 9.522% mass loss in the TG traces as well. As the heating temperature is over 500 ��, the mass of powder decreases slightly with the increase of the heating temperature, which is related to the decomposition of sulfate group adsorbed in the titania precursor. A small endothermic peak appeared at 663.1 �� in the DTA trace corresponding to the anatase to rutile phase transformation point. During the heating process of powder, two main decomposition reactions [11] taken place are described as follows:
TiO2?xSO3?yH2O��TiO2+xSO3��+yH2O�� (2)
2AgNO3��2Ag+2NO2��+O2�� (3)

Fig.1 TG-DTA curves of Ag/TiO2 powders
3.2 XRD analysis
XRD patterns of the powder samples calcined at different temperatures in air are shown in Fig.2. It can be seen that there are three peaks at 2�� values of 28.1?, 31.1? and 33.8? corresponding to silver sulfate. This indicates that sliver ions convert into stable silver sulfate, which are not decomposed into metal silver or silver oxide even being heated at 700 ��.

Fig.2 X-ray diffraction of powders calcined at different temperatures
When the composite powders are calcined at 400 ��, the anatase phase appears. With increasing heating temperature, the diffraction peaks of titania are more intense and narrow, which means that titania grains are crystallized and the diameter of titania grain increases. The average diameters of titania grain at various temperatures calculated by the Scherrer law are listed in Table 1. It can be seen that the average diameter of titania grain increases from 14 nm to 23 nm as the heating temperature increases from 400 �� to 700 ��. During the heat treatment process, the composite particle agglomerates and forms big particle, resulting in the decrease in the specific surface area of composite powders. When the heating temperature increases from 400 �� to 700 ��, the specific surface area of composite powders decreases from 63 m2/g to 38 m2/g. The rutile phase appears when the powder is calcined at 700 ��, but a considerable amount of anatase remains in the powder.
Table 1 Effect of heating temperature on average sizes of titania grain and SSA of silver-doped titania

3.3 SEM analysis
The SEM photographs of silver-doped titania powders calcined at different temperatures are shown in Fig.3. It can be seen that thermal treatment promotes the diversification of the morphology of silver-doped titania powders. The powder calcined at 400 �� is an agglomerated powder consisting of spherical nano- particle and its surface is rough, and many micropores are presented among the particles. When the powder is calcined at 500 ��, the nano-particle disappears and the micropore volume decreases. As the calcined temperature is set at 600 ��, the particle is crystallized well with smooth surface and diameter of 0.2-0.3 ��m. With the further increase of calcining temperature, the composite particles aggregate each other to form bigger particles.

Fig.3 SEM photographs of Ag/TiO2 powers calcined at different temperature: (a) 400 ��; (b) 500 ��; (c) 600 ��; (d) 700 ��
During the drying and calcination process with the elimination of liquid substance and the crystallization of anatase phase, the uniformly dispersed silver ions would gradually migrate from the center of anatase grains to the surface and further to the surface of the titania powder under the action of heat. Silver ion with the high redox potential is unstable and easily transformed to black metallic silver or brown silver oxide[7, 12-15], which turns the color of samples into dark. The higher the temperature, the darker the color of the sample. In experiments, it is found that the samples calcined at relatively low temperature are whiter than those calcined at relatively high temperature; and this result is consistent with the previous analysis. However, when the samples are exposed in natural light for a week, the samples calcined at relatively low temperature is darker than those calcined at relatively high temperature, which indicates that more black metallic silver and brown silver oxide clusters form within the network of titania calcined at the relatively low temperature after illumination. This may be attributed to the fact that titania particles are not completely densified at relatively low temperature. Silver ions are not completely trapped in the titania particles and are metallized easily on the surface of titania particles.
3.4 Release of silver ions from particles
The antibacterial activity of silver-doped titania is closely related to the concentrations of silver ion around the surface of the specimen. Composite powder exhibits stronger antibacterial activity as more silver ions are released from powder; thus, the release rate of silver ion of composite powder becomes a main factor to evaluate the antibacterial activity. The concentration of silver ion as a function of immersion time is shown in Fig.4. It can be seen that the concentrations of silver ion increase with the lapse of immersing time. The concentration of silver ion increases with the lapse of immersing time. The concentration of sliver ions increases sharply within the first day, and the amount of silver ion released within the first day is higher than that released in the next 7 days.

Fig.4 Ag+ release as function of time and concentration of composite powers calcined at different temperatures
The release of silver ion is also affected by the calcination temperature, and the amount of silver ion released decreases with increasing the calcination temperature. This is attributed to the fact that the titania grains aggregate each other to form large grains and the silver ions trap in the composite powder during thermal treatment, thereby less silver ions can be released from the powders into the water. Moreover, silver ion is unstable and transforms easily into black metallic silver or brown silver oxide during thermal treatment, resulting in the decrease of the release rate of silver ion.
3.5 Antibacterial activity test
The result of the antibacterial activity test of silver-doped titania powders calcined at various temperatures against E. coli is presented in Fig.5. It can be seen that the powders show strong antibacterial activity against E. coli. The number of surviving bacteria decreases rapidly with the lapse of time. More than half of bacteria are killed when they are exposed to the silver-doped titania powders for 6 h. After the exposure to the powders for 12 h, nearly all bacteria are killed. The composite powder calcined at relatively low temperature is stronger than that calcined at relatively high temperature. This is related to the release rate of silver ion of composite powder calcined at various temperatures.

Fig.5 Colony forming ability of E. coli cultured for various periods in water containing Ag/TiO2 powders
The photographs of the antibacterial activity of silver-doped titania powder against E. coli and S. aureus for 24 h are shown in Fig.6. It can be seen that neither E. coli nor S. aureus can survive in solution containing the composite powder with the exposure of 24 h, but a great number of bacteria are survivable in the plate with the absence of composite powders. The mechanism of sterilization of silver ions on E. coli and S. aureus was reported[13]. Silver ion can adsorb the protein on the surface of the bacterial membrane, influence membrane synthesis with S��Ag bonds and inhibit the DNA synthesis by direct binding on the bacterial DNA and finally result in the death of bacteria[13-14].
Fig.6 Test results of antibacterial effects: (a) E. coli incubated without Ag/TiO2 powders; (b) E. coli incubated without Ag/TiO2 powders calcined at 700 ��; (c) S. aureus incubated without Ag/TiO2 powders; (d) S. aureus incubated with Ag/TiO2 powders calcined at 700 ��
4 Conclusions
1) With the increase of the calcination temperature, the adsorbed water, the surface hydroxyl group, the structural hydroxyl group, ![]() group and
group and ![]() group are lost from silver-doped powder. Titania transforms from amorphous to anatase phase, and then transforms from anatase phase to rutile phase as the heating temperature is increased to 700 ��.
group are lost from silver-doped powder. Titania transforms from amorphous to anatase phase, and then transforms from anatase phase to rutile phase as the heating temperature is increased to 700 ��.
2) The particle size increases and the specific surface area decreases with the increase of the calcination temperature. The grains of titania agglomerate each other to form large grains during themal treatment, and various morphologies of composite powder calcined at different temperatures are obtained.
3) The release rate of silver ion of composite powder is influenced by the calcination temperature. The release rate of silver ion of powder heated at low temperature is larger than that of powder heated at higher temperature. The composite powders exhibit excellent antibacterial activity against E. coli and S. aureus, and the antibacterial activity of powders weakens slightly with the increase of the heating temperature.
References
[1] PHANI G, TULLOCH G, VITTORIO D, SKRYABIN I. Titania solar cells: New photovoltaic technology [J]. Renewable Energy, 2001, 22: 303-309.
[2] VICENTE G S, MORALES A, GUTIERREZ M T. Sol-gel TiO2 antireflective films for textured monocrystalline silicon solar cells [J]. Thin Solid Films, 2002, 403: 335-338.
[3] SEKIYA T, KAMEI S, KURITA S. Luminescence of anatase TiO2 single crystals annealed in oxygen atmosphere [J]. J Lumin, 2000, 87: 1140-1142.
[4] PAULOSE M, GOPAL K M, VARGHESE O K, SHANKAR K, GRIMES C A. Visible light photoelectrochemical and water �Cphotoelectrons properties of titania nanotube arrays [J]. J photochemistry and photobiology A: Chemistry, 2006, 178: 8-15.
[5] HUANG Z, MANESS P C, BLAKE D M, EDWARD J W, SHARON L S, WILLIAM A J. Bactericidal mode of titanium dioxide photocatalysis [J]. J Photochemistry and Photobiology A: Chemistry, 2000, 130: 163-170.
[6] HONG Jing-Ping WEI Chu, CHEN Mu-hua. Preparation of novel titania supported palladium catalysis for selective hydrogenation of acetylene to ethylene [J]. Catalysis Communications, 2007, 8: 593-597.
[7] ZHANG Fu-xiang, CHEN Ji-xin, ZHANG Xiu. Simple and low-cost preparation method for highly dispersed Pd/TiO2 catalysts [J]. Catalysis Today, 2004, 93: 645-650.
[8] VAMATHEVAN V, TSE H, AMALA R. Effects of Fe3+ and Ag+ ions on the photocatalytic degradation of sucrose in water [J]. Catalysis Today, 2001, 68: 201-208.
[9] HE C, YU Y, HU X F, LARBOT A. Influence of silver doping on the photocatalytic activity of titania films [J]. Applied Surface Science, 2002, 200: 239-247.
[10] ARABATZIS I M, STERGIOPOULOS T, BERNARD M C, LABOU D, NEOPHYTIDY S G, FALARAS P. Silver-modified titanium dioxide thin films for efficient photodegradation of methyl orange [J]. Applied Catalysis B: Environmental, 2003, 42: 187-240.
[11] GOLDSMITH A, WATERMAN E, HIRSCHHORN H J. Handbook of thermophsical properties of solid materials [M]. Vol.��. London: Ceramics Pergamon Press Ltd, 1961: 237-240.
[12] HE C, YU Y, HU X F, LARBOT A. Effect of silver doping on the phase transformation and grain growth of sol- gel titania powder [J]. Journal of the European Ceramic Society, 2003, 23(9): 1457-1464.
[13] FENG Q L, WU J, CHEN G Q, CUI F Z, KIM T N, KIM J O. A mechanistic study of the antibacterial effect of silver ions on E. coli and Staphylococcus aureus [J]. J Biomed Mater Res, 2000, 52: 662-668.
[14] YURANOVA T, RINCON A G, BOZZI A, PARRA S PNLGARIN C, ALBERS P, KIWI J. Antibacterial textiles prepared by RF-plasma and vacuum-UV mediated deposition of silver [J]. Journal of Photochemistry and Photobiology A: Chemistry, 2003, 161: 27-34.
[15] YOSHINARI M, ODA Y, KATO T, OKUDA K. Influence of surface modifications to titanium on antibacterial activity in vitro [J]. Biomaterials, 2001, 22: 2043-2048.
Foundation item: Project(04GK2007) supported by the Key Project of Scientific and Technological Department of Human Province, China
Corresponding author: CHAI Li-yuan; Tel: +86-731-8836804, Fax: +86-731-8710171; E-mail: lychai@mail.csu.edu.cn
(Edited by YANG Bing)


